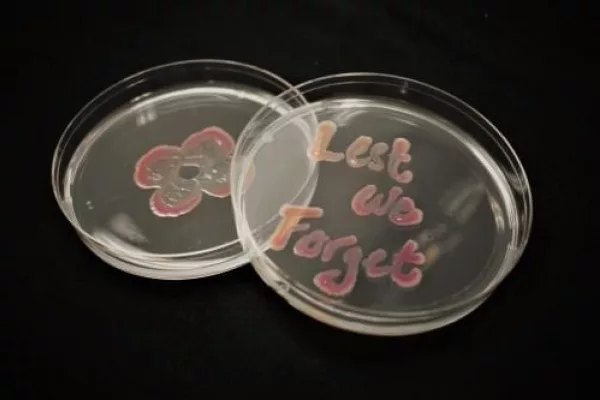
Remembrance Day
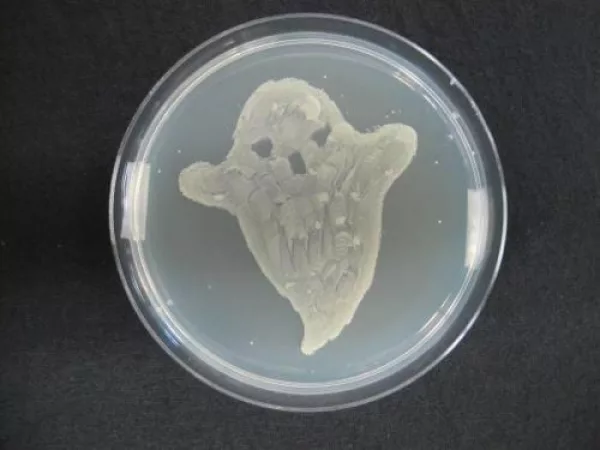
Scary Bacteria
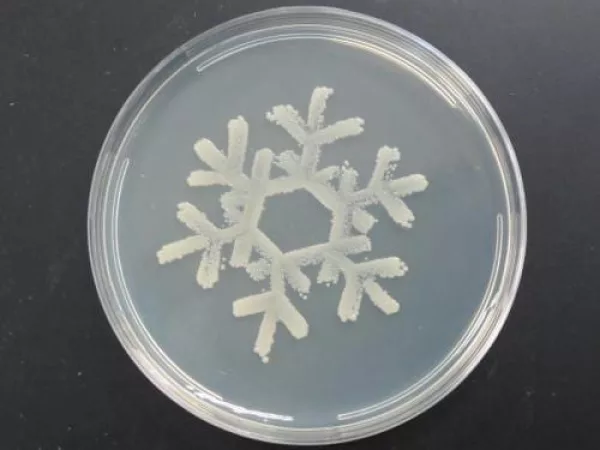
Bacterial snowflake using E. coli
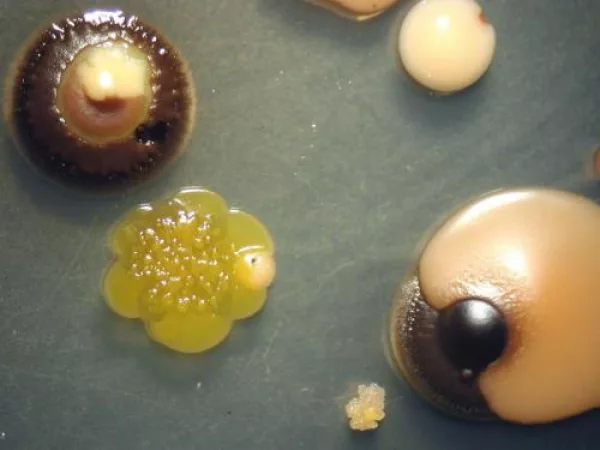
Bacterial Isolation
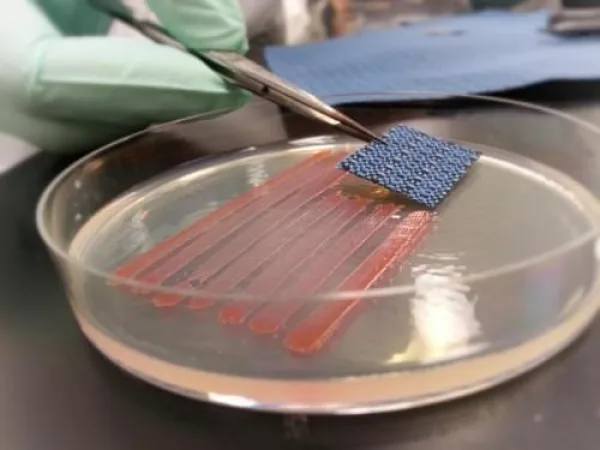
Happy Independance Day using bacteria
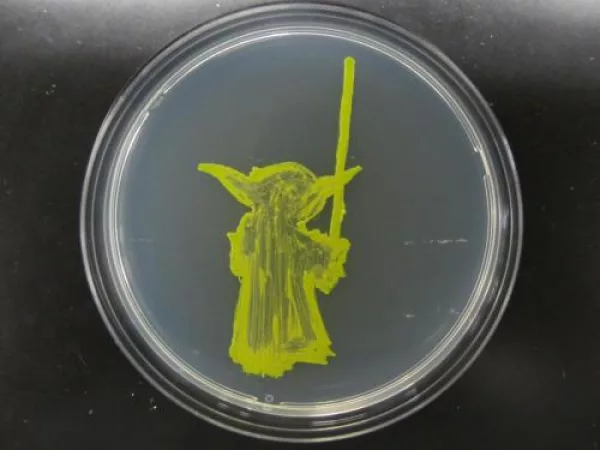
Yoda using algae
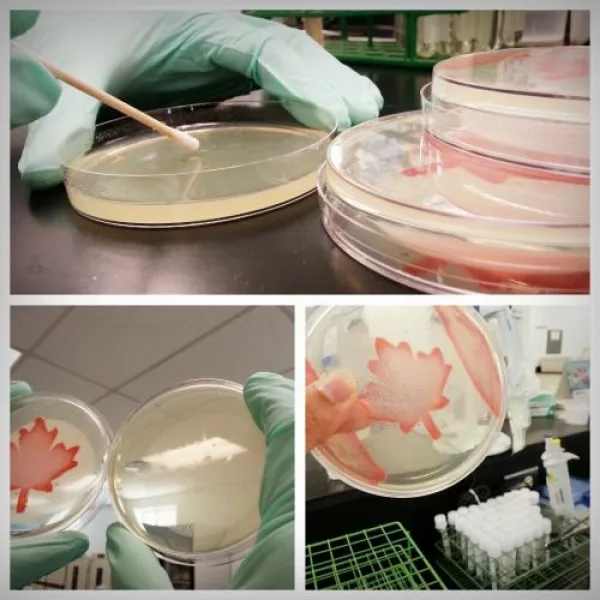
Canadian flag using Serratia marcescens

![Remembrance Day]()
Remembrance Day
Let us remember those who served our country. Visit mypoppy.ca to donate!
![Fungal Christmas Tree]()
Fungal Christmas Tree
Christmas tree grown using fungus
![Christmas Tree using Penicillium citrinum]()
Christmas Tree using Penicillium citrinum
Christmas Tree created using the fungus Penicillium citrinum
![Olaf using E. coli]()
Olaf using E. coli
Created using the bacteria E. coli
![Bacterial snowflake using E. coli]()
Bacterial snowflake using E. coli
Created using the bacteria E. coli
![Bacterial Isolation]()
Bacterial Isolation
Beautiful bacterial isolation from a contaminated sample
![Happy 4th of July using bacteria]()
Happy 4th of July using bacteria
American Flag created using Serratia marcescens
![Happy Independance Day using bacteria]()
Happy Independance Day using bacteria
American Flag using the bacteria Serratia marcescens
![Yoda using algae]()
Yoda using algae
Created using the algal organism Chlorella vulgaris
![Canadian flag using Serratia marcescens]()
Canadian flag using Serratia marcescens
Happy Canada Day from Thomson Research Associates
![Canadian flag using Serratia marcescens]()
Canadian flag using Serratia marcescens
Canadian flag grown using the Serratia marcescens bacterial organism, Thomson Research Associates
![Superman logo using Serratia marcescens]()
Superman logo using Serratia marcescens
Superman logo using Serratia marcescens, Thomson Reseach Associates